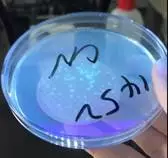

銅綠假單胞菌(Pseudomonas aeruginosa)是一種重要的水源性條件致病菌,廣泛存在于各類型水中,對(duì)消毒劑、干燥、紫外線燈理化因素具有較強(qiáng)的抵抗力,可引起急性腸道炎、腦膜炎、敗血癥和皮膚炎癥等疾病。近年來(lái),銅綠假單胞菌污染桶裝水的情況報(bào)道較多,是市面上包裝飲用水最容易出現(xiàn)的質(zhì)量問(wèn)題;2018年山東、江蘇、貴州、廣東等多省市瓶(桶)裝飲用水不合格率高發(fā),主因是銅綠假單胞菌超標(biāo)嚴(yán)重,該項(xiàng)目政府抽檢不合格率遠(yuǎn)超其他抽檢項(xiàng)目,質(zhì)量安全問(wèn)題十分嚴(yán)重,主要原因是生產(chǎn)企業(yè)沒(méi)有做好日常生產(chǎn)過(guò)程的微生物監(jiān)控,生產(chǎn)過(guò)程的消毒效果缺乏準(zhǔn)確的驗(yàn)證方法,使得生產(chǎn)的產(chǎn)品質(zhì)量失控。
GB8538-2016食品安全國(guó)家標(biāo)準(zhǔn) 飲用天然礦泉水檢驗(yàn)方法是國(guó)家最新公布的針對(duì)包裝飲用水銅綠假單胞菌的檢驗(yàn)方法,檢驗(yàn)程序如下:
標(biāo)準(zhǔn)的檢測(cè)過(guò)程寫(xiě)的比較精煉,對(duì)于一般生產(chǎn)企業(yè)的檢測(cè)人員來(lái)說(shuō)在實(shí)際的檢測(cè)過(guò)程中,會(huì)遇到比較多的問(wèn)題,以下來(lái)對(duì)其中的可能的檢測(cè)難點(diǎn)一一說(shuō)明并推薦相應(yīng)的解決辦法。
操作步驟
1 水樣過(guò)濾
取好的水樣需在100級(jí)的潔凈工作臺(tái)用0.45um的濾膜進(jìn)行抽濾,將微生物截留在濾膜上,再將濾膜貼在CN瓊脂培養(yǎng)基上進(jìn)行培養(yǎng),應(yīng)避免在濾膜和培養(yǎng)基之間夾留氣泡。
這個(gè)步驟中有兩個(gè)方面檢測(cè)方法中未說(shuō)明,一是采用何種濾器和如何滅菌,二是濾膜如何滅菌。
包裝水生產(chǎn)企業(yè)可以購(gòu)買專用的多聯(lián)不銹鋼過(guò)濾系統(tǒng),一般材質(zhì)是不銹鋼的,可以用牛皮紙包好后直接放入滅菌鍋內(nèi)進(jìn)行滅菌;也可以購(gòu)買常見(jiàn)的砂芯過(guò)濾器,同樣可以用牛皮紙包好后放入滅菌鍋滅菌;如果需要使用的濾器數(shù)量較多,可以采用高溫火焰噴槍灼燒方式滅菌,也可起到滅菌效果。濾膜可采用一次性無(wú)菌濾膜。

環(huán)凱多聯(lián)不銹鋼過(guò)濾系統(tǒng)

無(wú)菌微孔濾膜
2 濾膜在CN瓊脂培養(yǎng)和觀察
CN瓊脂培養(yǎng)后的菌落形態(tài)分以下三種,其它情況為非銅綠假單胞菌:
(1)藍(lán)色或綠色的典型可疑菌落,直接做綠膿菌素的確證性實(shí)驗(yàn),這個(gè)現(xiàn)象比較明顯,也容易辨認(rèn);

CN培養(yǎng)基上綠色菌落

綠膿菌素確證
(2)非藍(lán)綠色而在365nm紫外燈照射下產(chǎn)熒光的菌落,這種類型的可疑菌落需進(jìn)行乙酰胺肉湯確證性實(shí)驗(yàn);
CN培養(yǎng)基上非藍(lán)綠色而在365nm紫外燈照射下產(chǎn)熒光的菌落

乙酰胺確證試驗(yàn)
(3)是紅褐色菌落紫外燈照射下也不產(chǎn)熒光,需進(jìn)行氧化酶測(cè)試、乙酰胺液體培養(yǎng)基確證,金氏B培養(yǎng)基確證。
所有三種情況均需接種到營(yíng)養(yǎng)瓊脂培養(yǎng)基上進(jìn)行純化。
根據(jù)日常檢測(cè)數(shù)據(jù)的統(tǒng)計(jì),前兩種的情況較多,第三種情況最少,而第二種即非藍(lán)/綠色的產(chǎn)熒光的菌落最具有迷惑性,也是檢驗(yàn)的難點(diǎn)所在,需要特別仔細(xì)的進(jìn)行驗(yàn)證。
典型菌落的形態(tài)周圍呈現(xiàn)融化的狀態(tài),菌落數(shù)較少的情況下,劃線純化比較簡(jiǎn)單;菌落數(shù)較多的情況劃線就比較麻煩了,因?yàn)榈谝环N典型可疑菌落是直接目測(cè)能看到的,而第二種情況產(chǎn)熒光是需要在360nm的紫外燈照射下才能看見(jiàn)是否產(chǎn)熒光,這就會(huì)可能導(dǎo)致劃線純化的時(shí)候可疑和典型菌落出現(xiàn)混淆錯(cuò)劃的情況,會(huì)導(dǎo)致結(jié)果的截然不同。例如:挑取藍(lán)綠色可疑菌落純化時(shí),因菌落溶解狀擴(kuò)大,可能挑取時(shí)不僅挑取到了藍(lán)綠色可疑菌落,還挑取到其他類型可疑菌落,純化后確證就可能導(dǎo)致結(jié)果完全改變的情況,解決辦法是在這種菌落較多的情況下,可以采取計(jì)數(shù)后分開(kāi)再在CN瓊脂平板上劃線一次,先在CN瓊脂平板上分離中上述幾種菌落的單個(gè)菌落,再劃線接種到營(yíng)養(yǎng)瓊脂平板上純化后進(jìn)行確證試驗(yàn),已避免因挑取典型菌落出現(xiàn)差錯(cuò)導(dǎo)致結(jié)果的偏差。
3 確證性試驗(yàn)
這里需特別注意的是上述的第二種情況,即非藍(lán)/綠色產(chǎn)熒光的可疑菌落的產(chǎn)氨實(shí)驗(yàn):
純培養(yǎng)物接種到乙酰胺液體培養(yǎng)基36℃培養(yǎng)20~24h后,滴加1~2滴鈉氏試劑,檢查產(chǎn)氨實(shí)驗(yàn),有出現(xiàn)從深黃色到磚紅色的顏色變化,則為陽(yáng)性,否則為陰性。
在實(shí)際過(guò)程中會(huì)發(fā)現(xiàn)確證試驗(yàn)出現(xiàn)這種顏色變化過(guò)程的比例很高,是很多都是陽(yáng)性結(jié)果
經(jīng)過(guò)使用生化試劑條鑒定發(fā)現(xiàn)有近六成的比例并不是銅綠假單胞菌,是什么原因呢,主要是時(shí)間的問(wèn)題,時(shí)間比較久時(shí),磚紅色出現(xiàn)的幾率比較高,會(huì)影響檢測(cè)人員的判斷,建議在3~5分鐘內(nèi)進(jìn)行觀察,并且一定要與陽(yáng)性和陰性對(duì)照菌株進(jìn)行比較觀察,可有效降低誤判。另外推薦一種簡(jiǎn)單的方法:如覺(jué)得還有疑問(wèn)不能判定,可以從純培養(yǎng)物接種劃線到固體乙酰胺培養(yǎng)基進(jìn)行培養(yǎng),銅綠假單胞菌在固體培養(yǎng)基上的特征是灰白色,扁平,邊緣不整齊,菌落周圍培養(yǎng)基略帶粉紅色,可以結(jié)合固體和液體培養(yǎng)基的生長(zhǎng)特征和現(xiàn)象進(jìn)行判定,誤判基本可以消除,此方法成本很低,一般的生產(chǎn)企業(yè)可以使用。
銅綠假單胞菌的污染主要來(lái)自三個(gè)方面,一是水源的污染,二是加工過(guò)程的污染,三是包裝材料的污染,作為生產(chǎn)企業(yè),需要通過(guò)提高自身的檢測(cè)能力,分別監(jiān)測(cè)這三個(gè)方面的污染情況,采取有效的消毒滅菌方式,并驗(yàn)證滅菌效果,可確保生產(chǎn)的產(chǎn)品質(zhì)量安全有保障。
GB8538-2016銅綠假單胞菌檢驗(yàn)操作過(guò)程中要考慮多種因素,實(shí)驗(yàn)周期長(zhǎng),對(duì)實(shí)驗(yàn)人員專業(yè)水平要求高。下面給大家介紹一種操作簡(jiǎn)便、檢出率高的快檢方法——銅綠假單胞菌恒溫?zé)晒夂怂峥焖贆z測(cè)試劑盒。
1 銅綠假單胞菌恒溫?zé)晒夂怂峥焖贆z測(cè)方法

與傳統(tǒng)檢測(cè)方法相比,省去繁瑣的可疑菌落逐步確證的工作,一步判讀結(jié)果,縮短結(jié)果報(bào)告時(shí)間,且實(shí)驗(yàn)操作對(duì)檢驗(yàn)人員工作經(jīng)驗(yàn)要求不高!
2 環(huán)凱銅綠假單胞菌核酸檢測(cè)試劑盒組成

3 銅綠假單胞菌快速檢測(cè)所需試劑、儀器及耗材列表

